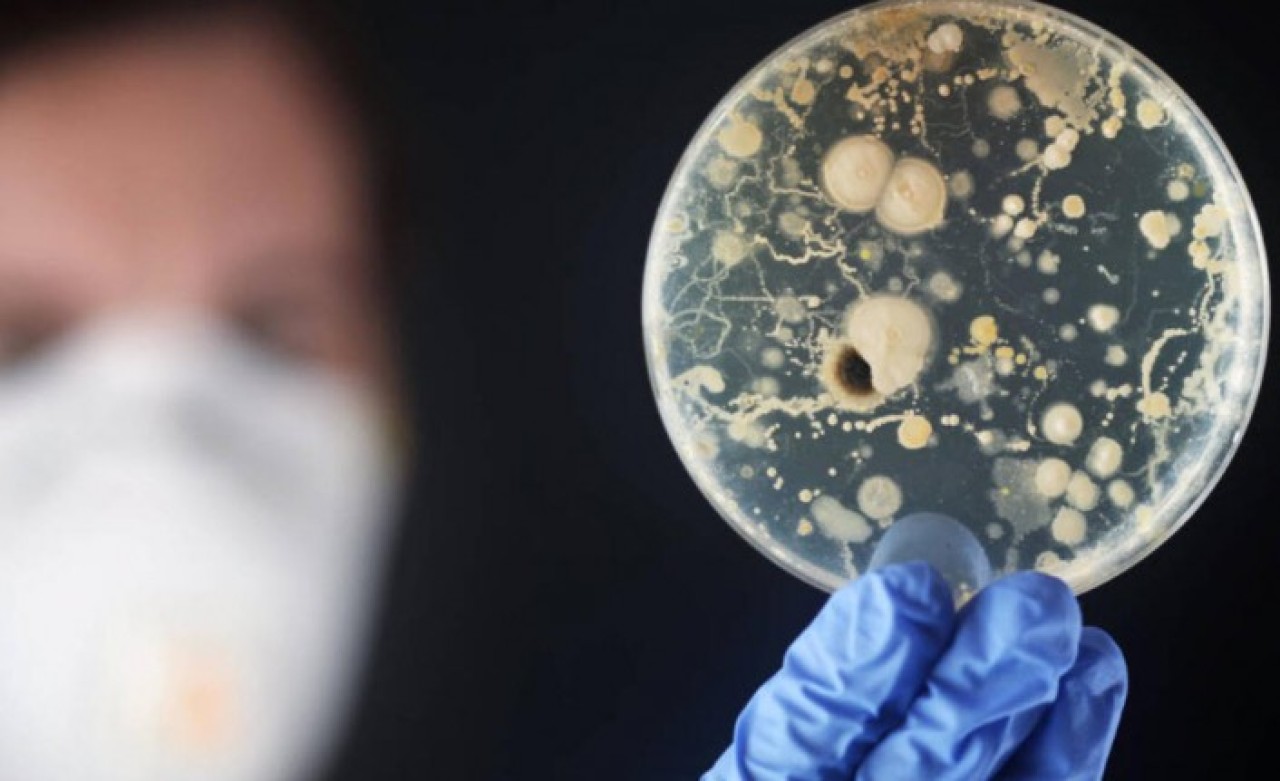
Beyin yiyen amip yeniden ortaya çıktı: Havuzdan bulaşıp,  1 haftada öldürüyor!

Tek hücreli amip, beyinde enfeksiyona yol açıyor ve vakalar genellikle ölümcül oluyor. Çoğunlukla göl ve nehir gibi tatlı sularda bulunan tek hücreli Naegleria fowleri, sadece burun yoluyla bulaşıyor ve insandan insana geçmiyor.
DOH (Florida Sağlık Dairesi), bu vakada hastalığın nasıl bulaştığını ve hastanın durumu hakkında ayrıntı vermedi. Enfeksiyonlar ABD'nin güney eyaletlerinde görülüyor. Florida'da 1962'den beri sadece 37 vaka rapor edildi.
Ancak enfeksiyonun ölümcül olması nedeniyle DOH(Florida Sağlık Dairesi), Hillsborough bölgesinde yaşayanlar için uyarı yayımladı, çeşmeler, göl, nehir, yapay göl ve kanallar gibi su kaynaklarında dikkatli olunması çağrısı yaptı.
Burunlarına Naegleria fowleri kaçan kişilerde yüksek ateş, mide bulantısı, kusma, boyun tutulması ve baş ağrısı gibi belirtiler görülüyor. Hastalar genellikle bir hafta içinde ölüyor. DOH, hastalığın çok hızlı ilerlemesi nedeniyle bu belirtilerin görüldüğü kişilerin acilen sağlık kuruluşlarına başvurmalarını istedi.
Uzmanlar, hızla beyin dokusunu yok eden Naegleria fowleri'nin jeotermal sularda ve iyi klorlanmamış havuz sularında da bulunabileceğini söylüyor. Naegleria fowleri'nin yutulması halinde hastalığa yol açmadığı belirtiliyor.